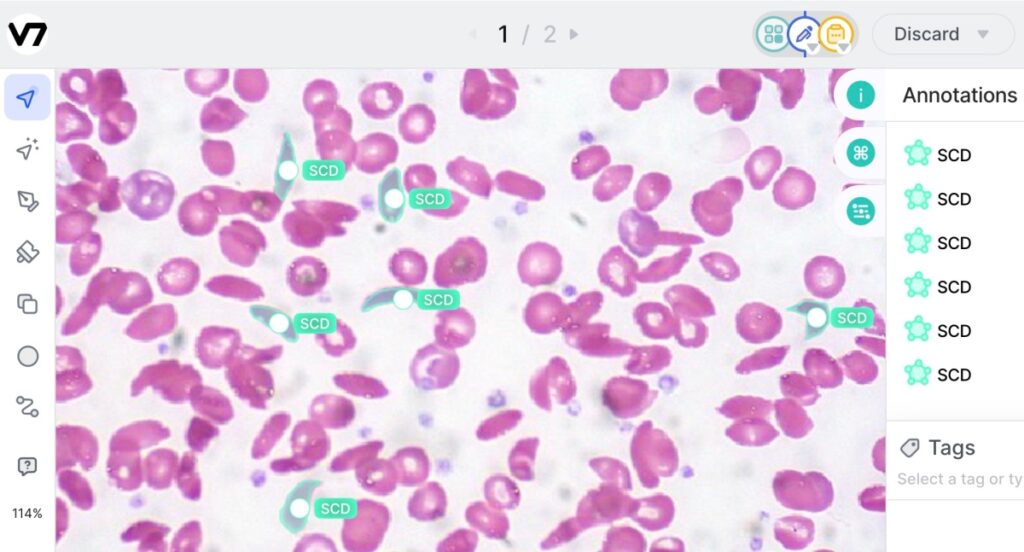
V7 obtiene $ 33 millones para automatizar datos de entrenamiento para modelos de IA de visión por computadora

La inteligencia artificial promete ayudar, y tal vez incluso reemplazar, a los humanos para llevar a cabo tareas cotidianas y resolver problemas que los humanos no han podido abordar, pero, irónicamente, la construcción de esa IA se enfrenta a un gran problema de escala. Es tan bueno como los modelos y los datos utilizados para entrenarlo, por lo que es necesario obtener e ingerir tesoros de datos cada vez más grandes. Pero anotar y manipular esos datos de entrenamiento requiere mucho tiempo y dinero, lo que ralentiza el trabajo o la efectividad general, y quizás ambas cosas.
Una startup llamada Laboratorios V7 cree que ha tenido un gran avance en la forma en que se aborda esto. Ha construido efectivamente modelos de entrenamiento para automatizar el entrenamiento de esos modelos. Hoy anuncia $ 33 millones en fondos para impulsar su crecimiento después de ver una gran demanda de sus servicios.
El enfoque actual de V7 es la visión por computadora y ayudar a identificar objetos. Dice que puede aprender qué hacer con solo 100 ejemplos anotados por humanos.
Actualmente tiene una fuerte tracción en los campos de la medicina y la ciencia, donde su plataforma se utiliza para ayudar a entrenar modelos de IA para acelerar, por ejemplo, cómo se identifican los cánceres y otros problemas en los escaneos. V7 también está comenzando a ver actividad con empresas tecnológicas y expertas en tecnología que buscan cómo aplicar su tecnología en una amplia variedad de otras aplicaciones, incluidas empresas que construyen motores para crear imágenes a partir de comandos de lenguaje natural y aplicaciones industriales. No está divulgando una lista completa de clientes y aquellos que evalúan su tecnología, pero la lista cuenta con más de 300 clientes e incluye a GE Healthcare, Paige AI y Siemens, junto con otras compañías Fortune 500 y empresas privadas más grandes.
Radical Ventures y Temasek lideran conjuntamente esta ronda, con la participación de Air Street Capital, Amadeus Capital Partners y Partech (tres patrocinadores anteriores), junto con varias personas destacadas en el mundo del aprendizaje automático y la IA. Incluyen a Francois Chollet (el creador de Keras, la biblioteca de red neuronal Python de código abierto), Oriol Vinyals (científico investigador principal de DeepMind), Jose Valim (creador del lenguaje de programación Elixir), Ashish Vaswani (cofundador de Adept AI que anteriormente había estado en Google Brain, donde inventó Transformers) y otros no identificados de OpenAI, Twitter y Amazon.
El director ejecutivo Alberto Rizzoli dijo en una entrevista que esta es la ronda de financiación de la Serie A más grande en esta categoría hasta la fecha, y se utilizará tanto para contratar más ingenieros como para desarrollar sus operaciones comerciales para asumir una nueva ola de interés de los clientes. con énfasis en los EE. UU. Se negó a comentar sobre la valoración, pero la puesta en marcha ahora ha recaudado alrededor de $ 36 millones, y por lo que entiendo, la valoración ahora es de alrededor de $ 200 millones.
Rizzoli también se negó a hablar sobre las cifras de ingresos, pero dijo que ARR se triplicó en 2022
Ha habido una serie de otras empresas emergentes que han surgido para ayudar a mejorar la eficiencia del entrenamiento de datos de IA y para abordar el área más amplia del modelado de IA. Superanotarque ha recaudado alrededor de $18 millones por Libro de tono, es uno de los competidores más cercanos de V7. (V7 incluso establece cómo se comparan los dos servicios). Otros incluyen escala IAque inicialmente se centró en el sector de la automoción, pero desde entonces se ha diversificado en otras áreas y ahora está valorado en alrededor de 7.000 millones de dólares; caja de etiquetas, que trabaja con empresas como Google y otras en el etiquetado de IA; y Colmenaque ahora está valorado en alrededor de $ 2 mil millones.
V7, nombrada en referencia a que la IA es la “séptima” área para procesar imágenes después de las seis áreas en el cerebro humano que forman su corteza visual (V1 a V6), y las otras confían en el hecho de que el modelo de entrenamiento es ineficiente y puede ser mejorado.
La USP específica de V7 es la automatización. Estima que alrededor del 80 % del tiempo de un equipo de ingeniería se dedica a administrar esos datos de capacitación: etiquetar, identificar cuándo algo está etiquetado incorrectamente, repensar las categorizaciones, etc., por lo que ha creado un modelo para automatizar ese proceso.
Llama al proceso que se le ocurrió “etiquetado programático”: utilizando IA de propósito general y sus propios algoritmos para segmentar y etiquetar imágenes, Rizzoli (quien cofundó la compañía con su CTO Simon Edwardsson) dice que solo se necesitan 100 “humanos”. “guiados” para que su etiquetado automático entre en acción.
Los inversores están apostando a que acortar el tiempo entre el diseño y la aplicación de los modelos de IA generará más negocios para la empresa. “La visión por computadora se está implementando a escala en todas las industrias, brindando innovación y avances, y un mercado de $ 50 mil millones en rápido crecimiento. Nuestra tesis para V7 es que la amplitud de las aplicaciones y la velocidad a la que se espera que se lancen nuevos productos en el mercado requieren una plataforma centralizada que conecte los modelos de IA, el código y los humanos en un ecosistema en bucle”, dijo Pierre Socha. , socio de Amadeus Capital Partners, en un comunicado.
V7 describe el proceso como “piloto automático”, pero el copiloto podría ser más preciso: la idea es que todo lo que se marque como poco claro se devuelva a los humanos para que lo evalúen y revisen. No reemplaza tanto a esos humanos como les facilita superar las cargas de trabajo de manera más eficiente. (También puede funcionar mejor que los humanos a veces, por lo que los dos utilizados en conjunto podrían ser útiles para verificar el trabajo del otro). A continuación, se muestra un ejemplo de cómo funciona el entrenamiento de imágenes en un escaneo para detectar neumonía.
Créditos de imagen: laboratorios v7
Teniendo en cuenta las muchas áreas en las que se aplica la IA para mejorar la forma en que se procesan y utilizan las imágenes, Rizzoli dijo que la decisión de duplicar el campo de la medicina inicialmente fue en parte para mantener los pies de la empresa en el suelo y centrarse en un mercado que podría Nunca he construido este tipo de tecnología internamente, pero definitivamente querría usarla.
“Decidimos centrarnos en verticales que ya están comercializando aplicaciones basadas en IA, o donde se está haciendo mucho trabajo en el procesamiento visual, pero por humanos”, dijo. “No queríamos estar atados a lanzamientos inesperados o proyectos que se están quedando sin grandes presupuestos de I+D porque eso significa que alguien busca resolver el problema por completo por sí mismo, y está haciendo algo más especializado, y es posible que desee tener su tecnología propia, no la de un tercero como nosotros.”
Y además de la búsqueda de las empresas de “su propia salsa secreta”, a veces los proyectos nunca pueden ver la luz del día fuera del laboratorio, agregó Rizzoli. “En cambio, estamos trabajando para aplicaciones reales”, dijo.
Créditos de imagen: Laboratorios V7 (Se abre en una nueva ventana)
En otro sentido, la puesta en marcha representa un cambio que estamos viendo en la forma en que las empresas obtienen y adoptan la información. Los inversores creen que el marco que está construyendo V7 podría cambiar potencialmente la forma en que esas empresas ingieren los datos en el futuro.
“V7 está bien posicionado para convertirse en el estándar de la industria para la gestión de datos en los flujos de trabajo modernos de IA”, dijo Parasvil Patel, socio de Radical Ventures, en un comunicado. Patel se une al tablero de V7 con esta ronda.
“La cantidad de problemas que ahora se pueden resolver con IA es enorme y crece rápidamente. A medida que las empresas de todos los tamaños compiten para capturar estas oportunidades, necesitan la mejor infraestructura de datos y modelos de su clase para ofrecer productos sobresalientes que mejoren continuamente y se adapten a las necesidades del mundo real”, agregó Nathan Benaich de Air Street Capital, en un comunicado. “Aquí es donde brilla el motor de datos AI de V7. No importa el sector o la aplicación, los clientes confían en V7 para enviar productos sólidos basados en IA más rápido que nunca. V7 empaqueta las mejores prácticas de la industria en rápida evolución en flujos de trabajo multijugador desde datos hasta modelos y productos”.